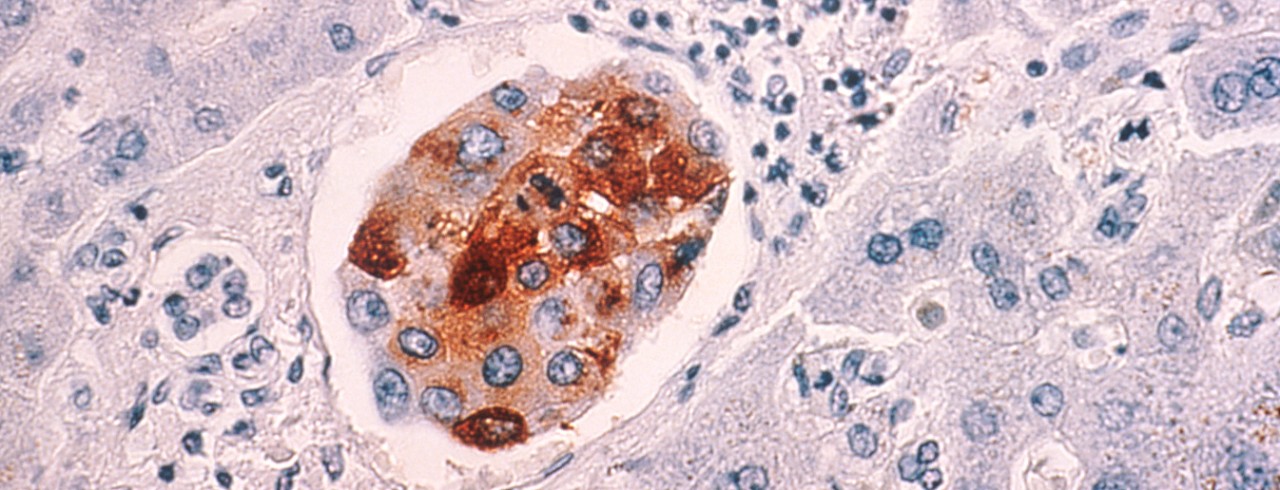
Breast cancer cells metastasized to the liver

Understanding breast cancer recurrence, metastatic spread
Researchers identify metabolic signature that predicts outcomes, opens potential therapeutic targets
Despite advancements in cancer detection and treatment, breast cancer that comes back or spreads still presents a challenge to researchers and oncologists.
The American Cancer Society estimates that 44,130 Americans died of recurrent or metastatic breast cancer in 2021. Ten-year survival rates for patients fall from 93% to 27% when the cancer comes back and to 7% when the cancer returns and spreads to other parts of the body.
Researchers from the University of Cincinnati and Cincinnati Children’s Hospital Medical Center are studying the biology of breast cancer recurrence. The team led by UC’s Susan Waltz, PhD, and Cincinnati Children’s Susanne Wells, PhD, published recent findings on biomarkers that help predict outcomes and could be targets for new treatments in the journal PLOS ONE Sept. 6.
Research background

Susan Waltz, PhD. Photo/University of Cincinnati
Waltz said the collaboration with Wells’ lab began around 15 years ago, as both research groups were studying different oncogenes, or genes that help accelerate cancer cell growth, called Ron and DEK.
“We showed that both Ron and DEK are very important in breast cancer and that both Ron and DEK are independently associated with poor overall survival in breast cancer patients,” said Waltz, professor in the Department of Cancer Biology in UC’s College of Medicine and a University of Cincinnati Cancer Center member. “We know that Ron and DEK as genes are very important in predicting breast cancer recurrence, but there’s not great drugs yet that can target at least DEK right now.”
The current research focused on the role of metabolic plasticity, or how metabolism in the body is constantly changing, which plays a significant role in how cancer grows and recurs.
“Our metabolism is ever-changing based on how we are designed genetically and also based on what we ingest and are exposed to,” said Wells, professor in the UC Department of Pediatrics, director of the Epithelial Carcinogenesis and Stem Cell Program at Cincinnati Children’s and a Cancer Center member. “And cancer cells love a certain metabolism that is called a cancer metabolism and promotes cancer formation and spread.”
Regulating metabolites is much easier than regulating genes. Hopefully someday we can treat these worst features of cancer by targeting cancer metabolism.
Susanne Wells, PhD
Study findings
The research team found that the Ron and DEK genes can regulate certain metabolites, substances made or used when the body breaks down food, drugs or chemicals in the process of metabolism, to help cancer cells grow and spread.
“So we went about and found changes in metabolites, and then took those changes and went back and figured out which enzymes were involved in regulating those metabolites,” Waltz said.

Susanne Wells, PhD. Photo/Cincinnati Children's Hospital Medical Center
By studying the enzymes involved, the team identified a metabolic signature that can help better predict outcomes for patients. In addition to being a helpful biomarker, the metabolic signature itself could be a potential target for new therapies.
“We can use those metabolic pathways to understand how we might be able to better treat cancer patients so that they’re not more susceptible to breast cancer recurrence,” Waltz said. “It could be dietary, it could be different ways of treating patients compared to the toxic drugs that we give patients now.”
For example, if a high level of a certain enzyme is predictive of better outcomes, nutritional supplements or other treatments can help promote that enzyme’s activity. Alternatively, if high levels of a certain metabolite predict worse outcomes, treatments can reduce that metabolite by blocking the function of relevant enzymes in that pathway.
“Regulating metabolites is much easier than regulating genes,” Wells said. “Now we are really opening up a path that is much wider than just targeting Ron and DEK. Hopefully someday we can treat these worst features of cancer by targeting cancer metabolism.”
It helps to invigorate lab members a little bit because they know that science isn't being done in a bubble. And it means a lot, because we took an idea that we both had and we worked together and made that idea come to fruition.
Susan Waltz, PhD
Waltz said further research will include looking at how Ron and DEK affect other molecules such as lipids, or fatty acids, that also play a role in metabolism. By further defining more specific metabolic signatures that align with breast cancer patient outcomes, even more avenues for new treatments may be found.
“In other words, which metabolite is most important in driving these poor outcomes and how do we target it,” Wells said.
Ongoing collaboration
Waltz and Wells said their labs’ partnership has gone beyond research and has included more collaborative discussions and training of students and lab staff.
“It’s been fun for my lab because I think research is best not done in a vacuum, and it’s really great when you have collaborators that take different perspectives on things,” Waltz said. “It helps to invigorate lab members a little bit because they know that science isn't being done in a bubble. And it means a lot, because we took an idea that we both had and we worked together and made that idea come to fruition.”
“It’s been really fun writing together, thinking together, but it’s also been fun bringing students and staff together,” Wells added. “It’s not that we’re adding up the contribution of each lab and achieving a little more, but it’s the synergistic effect of our tools and expertise.”
The researchers were also aided by the NMR-based Metabolomics Core at Cincinnati Children’s, a facility that provides state-of-the-art technology to researchers conducting metabolism-related research.
“This metabolomics facility is really a great bridge for different groups and laboratories that do metabolomics work and meet in the middle, both with Cincinnati Children’s and UC, so that’s very important,” Wells said.
Waltz and Wells particularly noted the work of Sara Vicente-Muñoz, co-first author on the study and Cincinnati Children’s research associate in the Metabolomics Core, in making research progress.
“Sara has really pushed the project forward,” Waltz said. “Based on the collaboration, we had to figure out ways to do things that haven’t been done at UC and Cincinnati Children’s to make them be done. And Sara has done that for us.”
Study co-authors also include Brian G. Hunt and Taylor E. Lange. This research was funded by National Cancer Institute grants R01 CA239697 awarded to Waltz and Wells and F31 CA228373 awarded to Hunt and Waltz. The authors claim no relevant conflicts of interest.
Featured photo at top of breast cancer cells metastasized to the liver. Photo courtesy of National Cancer Institute.
Related Stories
Sugar overload killing hearts
November 10, 2025
Two in five people will be told they have diabetes during their lifetime. And people who have diabetes are twice as likely to develop heart disease. One of the deadliest dangers? Diabetic cardiomyopathy. But groundbreaking University of Cincinnati research hopes to stop and even reverse the damage before it’s too late.
Is going nuclear the solution to Ohio’s energy costs?
November 10, 2025
The Ohio Capital Journal recently reported that as energy prices continue to climb, economists are weighing the benefits of going nuclear to curb costs. The publication dove into a Scioto Analysis survey of 18 economists to weigh the pros and cons of nuclear energy. One economist featured was Iryna Topolyan, PhD, professor of economics at the Carl H. Lindner College of Business.
App turns smartwatch into detector of structural heart disease
November 10, 2025
An app that uses an AI model to read a single-lead ECG from a smartwatch can detect structural heart disease, researchers reported at the 2025 Scientific Sessions of the American Heart Association. Although the technology requires further validation, researchers said it could help improve the identification of patients with heart failure, valvular conditions and left ventricular hypertrophy before they become symptomatic, which could improve the prognosis for people with these conditions.
